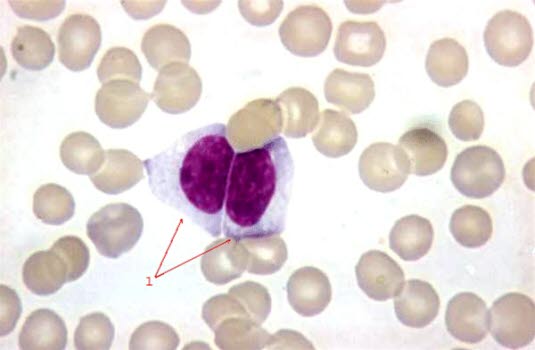
Mononukleose, McKinlay celler

Alt innhold er opphavsrettslig beskyttet. © Norsk Helseinformatikk
NHI.no arbeider etter Vær Varsom-plakatens regler for god presseskikk. NHI.no har ikke ansvar for innhold på eksterne nettsider som det lenkes til.
Ansvarlig redaktør
Terje Johannessen
Redaktør NHI.no
Merethe Kvam